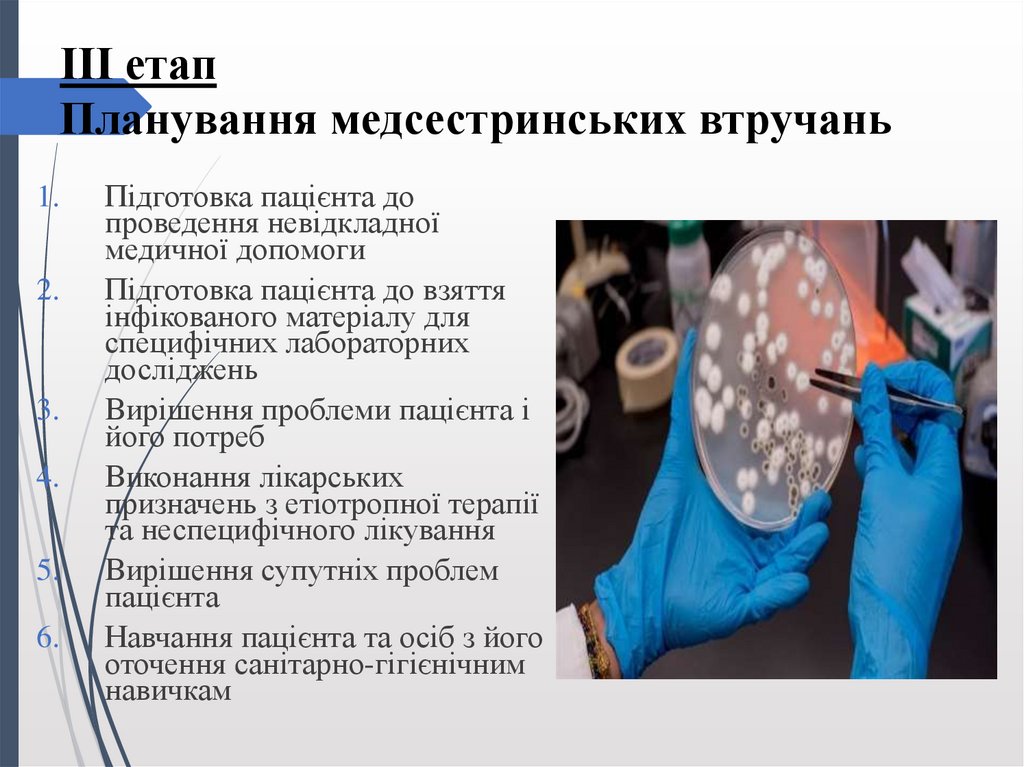

Similar presentations:
Харчові токсикоінфекції. Сальмонельоз. Ботулізм
1. Лекція 4
Харчові токсикоінфекції.Сальмонельоз. Ботулізм
2.
Харчові отруєнняМікробного
походження
бактеріальні
Немікробного
походження
грибкові
•Продуктами,
отруйними по своїй
природі
•Продуктами,
тимчасово отруйними
•Продуктами, які
мають отруйні домішки
3.
Харчові токсикоінфекції – це збірна групагострих інфекційних хвороб, що зумовлені
вживанням інфікованих різними мікроорганізмами
та їх токсинами продуктів харчування;
супроводжуються загальною інтоксикацією,
картиною гастроентериту, порушенням водноелектролітного обміну
4. Етіологія
СтрептококиСтафілококи
Сальмонели
Ентерококи
Клостридії
Протей
Деякі вібріони
5. Епідеміологія
хворі люди,тварини, бактеріоносії
Джерело і
резервуар збудника
грунт
Шлях зараження
харчовий
молочні
продукти
сприятливість
висока
салати
кондитерські
вироби
сезонність
літньо-осіння
6.
7. Медсестринський процес І етап – медсестринське обстеження
Скарги пацієнта:Нудота
Блювання
Підвищення температури тіла
Нападоподібний біль у
надчеревній ділянці,
в ділянці пупка, іноді
по всьому животу
8. Анамнестичні дані
1. Інкубаційний період – від 1 год до 1 доби2. Гострий початок
3. Швидке наростання інтоксикації
4. Швидкий зворотній розвиток хвороби
9. Об’єктивно
5.Язик сухий, із біло-сірим нальотом
Блювання
Після блювання з’являється пронос
Фекалії – водянисті, часто не містять патологічних
домішок
Можливий розвиток зневоднення
6.
Зниження АТ
1.
2.
3.
4.
10. ІІІ етап Планування медсестринських втручань
1.2.
3.
4.
5.
6.
Підготовка пацієнта до
проведення невідкладної
медичної допомоги
Підготовка пацієнта до взяття
інфікованого матеріалу для
специфічних лабораторних
досліджень
Вирішення проблеми пацієнта і
його потреб
Виконання лікарських
призначень з етіотропної терапії
та неспецифічного лікування
Вирішення супутніх проблем
пацієнта
Навчання пацієнта та осіб з його
оточення санітарно-гігієнічним
навичкам
11. Підготовка пацієнта та проведення невідкладної медичної допомоги
1.Негайне ефективне
промивання шлунка (до
чистих промивних вод)
великою кількістю рідини
(2% розчин натрію
гідрокарбонату), бажано
зондове
2.
Здійснення промивання
кишечника (постановка
очисної клізми, а при
важкому стані сифонної)
3.
При відсутності
випорожнень проносні
засоби
12. ІV етап. Реалізація плану медсестринських втручань
1. Взяття блювотних мас длябактеріологічного
дослідження
2. Взяття промивних вод
шлунку для
бактеріологічного
дослідження
3. Взяття залишків харчових
продуктів для
бактеріологічного
дослідження
4. Взяття крові з вени для
бактеріологічного
дослідження
5. Взяття крові з вени (5 мл) для
серологічного дослідження
13. Створення відповідно належних комфортних умов
1.2.
3.
Допомоги при блюванні, очищення ротової порожнини.
Забезпечити посудом для збирання блювотних мас
Систематичний контроль за частотою випорожнень, кількістю,
кольором, консистенцією, наявністю патологічних домішок
Виділити індивідуальне судно
14.
4.5.
6.
7.
Збирання блювотних мас, випорожнень в окремі ємкості
із мірними позначками (для обліку втрат рідини)
Систематичний контроль за самопочуттям; вимірювання
t тіла, пульсу, AT
Контроль та допомога в дотриманні чистоти шкіри,
ротової порожнини, рук, натільної і постільної білизни
Контроль та допомога в дотриманні дієти:
Перша доба голод, водно-чайна дієта
Через 2-3 дні розширення дієти (каші, протерті супи,
перетерте м’ясо, сухарі, компоти, кисіль, кефір)
15. Виконання лікарських призначень
1.2.
3.
4.
5.
Сорбенти (ентеросгель, активоване вугілля, поліфепан та ін)
Пероральні дезінтоксикаційні: ораліт (глюкосолан), регідрон
та ін.
Поліферментні препарати (панзинорм, фестал) та ін.
Парентеральна регідратація (при тяжких формах): в/в
крапельно ізотонічні розчини - "Квартасіль", "Трисіль",
"Хлосіль", "Дисіль" та ін.
Симптоматична терапія- в/м кордіамін, кофеїн
16. Ускладнення
1. Інфекційнотоксичний шок2. Гіповолемічний шок
3. Гостра ниркова
недостатність
4. Тромбоз
магістральних судин
17. Профілактика
1.2.
3.
4.
Декретованих осіб
виписують після
одноразового негативного
бактеріологічного
обстеження
Дотримання санітарногігієнічних правил
приготування та зберігання
харчових продуктів
Ветеринарний контроль
Недопущення до
приготування їжі осіб з
гнійничковими,
респіраторними
захворюваннями
18.
Сальмонельоз- це гостра зооантропонознаінфекційна хвороба, яка спричиняється бактеріями
з роду Salmonella і проявляється переважно
явищами гастроентериту та інтоксикації.
19. Етіологія
Збудник належить до роду SalmonellaІснує близько 2300 серотипів
сальмонел
Грамнегативна, рухлива паличка
Виділяє ентеротоксин
Добре росте на поживних
середовищах
Деякі види не чутливі до
антибіотиків
Добре зберігається у воді, грунті,
намулі, харчових продуктах
Чутливі до дезрозчинів, кип’ятіння
20. Епідеміологія
Джерело інфекції:хворі та бактеріоносії:
птахи (особливо водоплавні)
травоїдні тварини (корови,кози, вівці)
хижаки
гризуни
людина
21.
Механізм передачі- фекально-оральнийШляхи передачі:
Харчовий
Контактно-побутовий
Основні фактори передачі:
Яйця
М’ясо
Молоко
Сприятливість – висока (більш чутливі діти
раннього віку)
22.
КласифікаціяЗа клінічними формами:
1.Локалізована форма (гастроінтестінальна)
Гастрит
Гастроентерит
За перебігом:
Гастроентероколіт
Легкий
Ентероколіт
Середньої тяжкості
2. Генералізована форма
Важкий
Тифоподібна
Септична
3. Субклінічна (бактеріоносійство)
Гостре (до 3 місяців)
Хронічне (більше 3 місяців)
23. Медсестринський процес І етап- медсестринське обстеження
Скарги пацієнта:Нудота
Блювання з короткочасним
покращенням самопочуття
Болі в животі різної локалізації
Частий рідкі випорожнення
(фекалії водянисті, пінисті, з
великою кількістю слизу,
зеленого кольору, смердючі, у
вигляді «болотної твані»)
Озноб, підвищення температури
тіла
Загальна слабість
Головний біль
24. Анамнестичні дані
Інкубаційний період: 2 год – кілька днівГострий початок
Розлади випорожнень
Розлиті болі по всьому животу
При важкому перебігу: симптоми зневоднення
(порушення водно-електролітного обміну, колапс,
ціаноз, у дітей судоми)
25. Об’єктивно
Температура тіла 38-39 СТахікардія, гіпотензія
Язик сухий, обкладений білим нальотом
Живіт помірно здутий при пальпації
болючість у надчеревній і пупковій
ділянці
Блювотні маси водянисті, забарвлені
жовчю
Фекалії водянисті, пінисті, з домішками
слизу, зеленого кольору, смердючі
При зневодненні: сухість шкіри, спрага,
ціаноз, холодні кінцівки, колапс, у дітей
судоми.
26. ІІІ етап Планування медсестринських втручань
1.Підготовка пацієнта та проведення заходів першої
медичної допомоги
2.
Підготовка пацієнта та взяття інфікованого матеріалу
для специфічних лабораторних досліджень
3.
Вирішення проблем та потреб пацієнта
4.
Виконання лікарських призначень з етіотропної терапії
та неспецифічного лікування
5.
Вирішення супутніх проблем пацієнта
6.
Навчання пацієнта та його оточуючих елементам
санітарно-гігієнічних навичок
27. IV етап Реалізація плану медсестринських втручань
1.Промивання шлунка (спочатку чистою водою, потім відразу
содовим розчином до чистих промивних вод) Після цьогосорбенти
2.
Взяття промивних вод шлунка (50-100 мл першої порції) для
бактеріологічного дослідженння
3.
Взяття випорожнень, блювотних мас, промивних вод, сечі,
крові, жовчі для бактеріологічного дослідження
4.
Взяття залишків підозрілого продукту у стерильну банку для
бактеріологічного дослідження
28.
Створення належних комфортних умов по дотриманніпризначеного режиму
1. Надання допомоги при блюванні: після блювання забезпечити
очистку ротової порожнини.
2. Виділити індивідуальне судно.
3. Систематичний
контроль
за
самопочуттям:
вимірювання
температури тіла, пульсу, АТ.
4. Контроль та допомога в дотриманні чистоти шкіри, ротової
порожнини, рук, натільної і постільної білизни.
5. Збір блювотних мас, випорожнень в окремі ємкості із мірними
позначками для обліку втрат рідини.
6. Контроль та допомога в дотриманні дієти (спочатку щадна, потім
поступове розширення) з інтенсивним питтям.
7. Обтирання тіла при гарячці, переодяганння в сухий одяг, зігрівання
при ознобі.
8. Контроль за здійсненням поточної дезінфекції в палаті
29.
Виконання лікарських призначень1.
2.
3.
Перорально:
ентеросорбенти (ентеродез, ентеросорб, силард
та ін)
пиття сольових розчинів (ораліт, регідрон)
сальмонельозний бактеріофаг
бісептол, нітрофуранові (фуразолідон,
ніфуроксазид), похідні 8-оксихіноліну
(ентеросептол)
поліферментні препарати (фестал, панзинорм,
панкреатин),
вітаміни
біфідумбактерин,колібактерин, лактобактерин,
імодіум.
При наростанні зненводнення в/в крапельно
розчини (“Квартасіль”, “Трисіль”, “Ацесіль”),
5% розчин глюкози
При важкому перебігу – антибіотики (ампіцилін,
цефотаксим), глікококртикостероїди, серцеві
глікозиди
30. V етап Оцінка результатів медсестринських втручань та їх корекція
Зникнення нудоти та позивів до блюванняПрипинення блювання
Нормалізація випорожнень
Покращення апетиту, нормалізація загального стану
Відсутність болю в животі
31. Профілактика
Ветеринарно-санітарний нагляд за забоєм худоби і птиці,технологією обробки туш, транспортуванням і збереженням
м’ясних, молочних, рибних страв
Достатня термічна обробка мясних продуктів, яєць молока
32. Вакцинація тварин та птиці Дотримання правил особистої, харчової гігієни та санітарії Санітарно-освітня робота
•Вакцинація тварин та птиціДотримання правил особистої, харчової гігієни та санітарії
Санітарно-освітня робота
Своєчасне виявлення хворих та бактеріоносіїв,
дотримання правил виписки, облік в КІЗ
У вогнищі дезінфекція та обстеження контактних
33.
Ботулізм- гостра кишкова інфекційнахвороба, що спричинюється екзотоксинами
бактерії ботулізму, характеризується
ураженням нервової системи, порушенням
зору, ковтання, моторики кишок.
34.
Збудник – Clostridium botulinumoГ+ рухлива паличка з
заокругленими кінцями
oАнаероб
oПродукує екзотоксин
oІснує в 2-х формах:
Вегетативна
Спорова
35.
Збудник нестійкий до:Високих температур
Вегетативні форми гинуть
при кип’ятінні через 5хв
Значний вміст кухонної солі
і цукру пригнічують їх ріст
При несприятливих умовах
вегетативні форми
перетворюються в спори
(нагадуть «тенісні ракетки»)
Стійкий до:
Спори при 100ºС гинуть
через 4 год, при 120ºС- через
30хвилин.
36.
ЕпідеміологіяЗбудник ботулізму відноситься до сапрофітів грунту
Резервуар
інфекції
Травоїдні тварини
Рідше риби, молюски
Механіз
передачі
Фекально-оральний
Шлях
Харчовий
37.
Чинники передачі38.
Виділяютьботулізм:
Харчовий
Рановий
Немовлят
Неуточнений
39.
Анамнестичні дані:• Інкубаційний період від 2-3 год до 10 діб
(частіше 12-24 год)
• Чим коротший інкубаційний період- тим
важчий перебіг хвороби
• Особливість- відсутність гарячки або
субфебрилітет
40.
І етапМедсестринське обстеження
1.Починається раптово з симптомів
гастроентериту
2.Блювання часте, не приносить
полегшення
3.Сильна м’язова слабкість
4.Через декілька годин з’являється:
• Сухість в роті
• Нечітке бачення предметів,
двоїння в очах, «сітка перед
очима»
• Порушення ковтання
• Порушення мови
• Метеоризм, закреп
• Маскоподібне лице
• Опущення повіки, розширення
зіниць
41.
42. ІІ етап Медсестринська діагностика
двоїння в очахзниження гостроти зору
м'язова слабість
утруднене ковтання
захлинання рідиною
сухість слизових ротоглотки, спрага
помірне здуття живота, закрепи
утруднене дихання
43. ІІІ етап Планування медсестринських втручань
1.2.
3.
4.
5.
6.
Підготовка пацієнта до проведення невідкладної
медичної допомоги
Підготовка пацієнта до взяття інфікованого матеріалу
для специфічних лабораторних досліджень
Вирішення проблеми пацієнта і його потреб
Виконання лікарських призначень з етіотропної терапії
та неспецифічного лікування
Вирішення супутніх проблем пацієнта
Навчання пацієнта та осіб з його оточення санітарногігієнічним навичкам
44. IV етап Реалізація плану медсестринських втручань
Підготовка пацієнта до проведенняневідкладної медичної допомоги
1.
Термінове і незалежне від терміну хвороби
зондове промивання шлунка до чистих вод
при зараженні
2.
Введення через зонд сорбентів (активоване
вугілля, аеросил, силард тощо)
3.
Сифонні клізми при будь-якому шляху
зараження
45. IV етап Реалізація плану медсестринських втручань
Взяття матеріалу для специфічних досліджень1. Взяття для бактеріологічного дослідження і виявлення
ботулінічного токсину різного інфікованого матеріалу:
блювотних мас
промивних вод
випорожнень
сечі
залишків продуктів
вмісту ран
46.
2.Взяття крові з вени для
біологічної проби на
білих мишах
(для
виявлення
ботулотоксину)
3.
Підготовка пацієнта і
участь у додаткових
дослідженнях в
динаміці: ЕКГ, функція
зовнішнього дихання,
кислотно-основний
стан, консультації:
окуліста,
невропатолога,
отоларинголога
47. Створення пацієнтові належних комфортних умов дотримання призначеного режиму
1.2.
3.
4.
5.
6.
7.
Суворий ліжковий режим.
Створення пацієнтові умов максимального нервовопсихічного спокою ( уникати хвилювань, неприємних
емоцій, переживань)
Допомога пацієнтові при питті, рухах
Застосування газовідвідної трубки ( при метеоризмі)
При атонії сечового міхура- ввести м'який катетер
Зволоження та очищення ротової порожнини
У разі тяжких дихальних розладів показана трахеотомія
48.
7.Періодичне зміщення інтубаційної, трахеостомічної
трубки, зонда, катетера, щоб не утворювались пролежні
8.
Протягом першої доби не годують, пропонують пити
лужну мінеральну воду, фруктові соки, чай (до 2-3 л).
Далі механічно і хімічно щадна дієта
9.
При вираженому паралічі м'язів глотки- назогастральне
зондове харчування,
10. Постійний контроль за самопочуттям та загальним
станом пацієнта ( зором, мовою, ковтанням, диханням,
зникненням сухості в роті, зменшенням м'язової
слабості та ін)
49.
Введення сироватки за методом Безредки1.Спочатку вводять 0,1 мл сироватки, розведеної у 100 разів
внутрішньошкірно в середню третину внутрішньої
поверхні передпліччя.
2.За відсутноті реакції (папула і гіперемія менше 1 см) через
20-30 хвилин вводять 0,1 мл нерозведеної сироватки
підшкірно в зовнішню поверхню плеча.
3.Через 30-40 хвилин за відсутності реакції вводять
внутрішньом’язово всю дозу сироватки, попередньо
підігрітої до 36-37ºС.
50.
Виконання лікарських призначень1.
Антибактеріальна терапія
(левоміцетин, ампіцилін, тетрациклін,
цефалоспорини та ін.)
2.
Парентерально:
інфузійно-дезінтоксикаційна терапія
(в/в реополіглюкін, "Лактосіль", 5% р-н
глюкози, ізотонічний розчин хлориду
натрію, лазикс)
вітаміни (групи В, аскорбінова к-та)
серцево-судинні (сульфокамфокаїн,
серцеві глікозиди)
Якщо ковтання не порушене-достатнє
пиття ( до 3-3,5 л)
4.
5.
Для відновлення функції нервової
системи, дихання -прозерин,
галантамін, гіпербарична оксигенація
51.
При порушенні диханняз тахікардією, ціанозом
переведення на штучну
вентиляцію легень
через інтубацію або
трахеостомію ( в
залежності від ситуації)
52. V етап Оцінка результатів медсестринськив втручань та їх корекція
зникнення сухості у роті, тобто відновлення саліваціїзворотний розвиток клінічних проявів хвороби:
покращання зору
відновлення ковтання
зникнення м'язової слабості,
зникнення задишки
відновлення перистальтики кишок
зникнення метеоризму та ін
корекція м/с втручань при потребі
53. Профілактика Протиепідемічні заходи в осередку
Підозрілі продукти підлягають вилученню ілабораторному контролю
Усім особам, що їх вживали - промивання шлунка,
проносні, сифонна клізма, ентеросорбенти
Введення полівалентної сироватки
54. Загально санітарні заходи
Суворе дотримання санітарно-гігієнічних норм та правилпід час виготовлення, транспортування, зберігання
продуктів харчування, особливо консервів, ковбас,
копчених продуктів, рибних і м'ясних напівфабрикатів,
солоної та копченої риби, грибів тощо
55.
Бомбажні банки бракуютьсяПрофілактика забруднення землею харчової сировини і
готових продуктів

medicine
medicine








